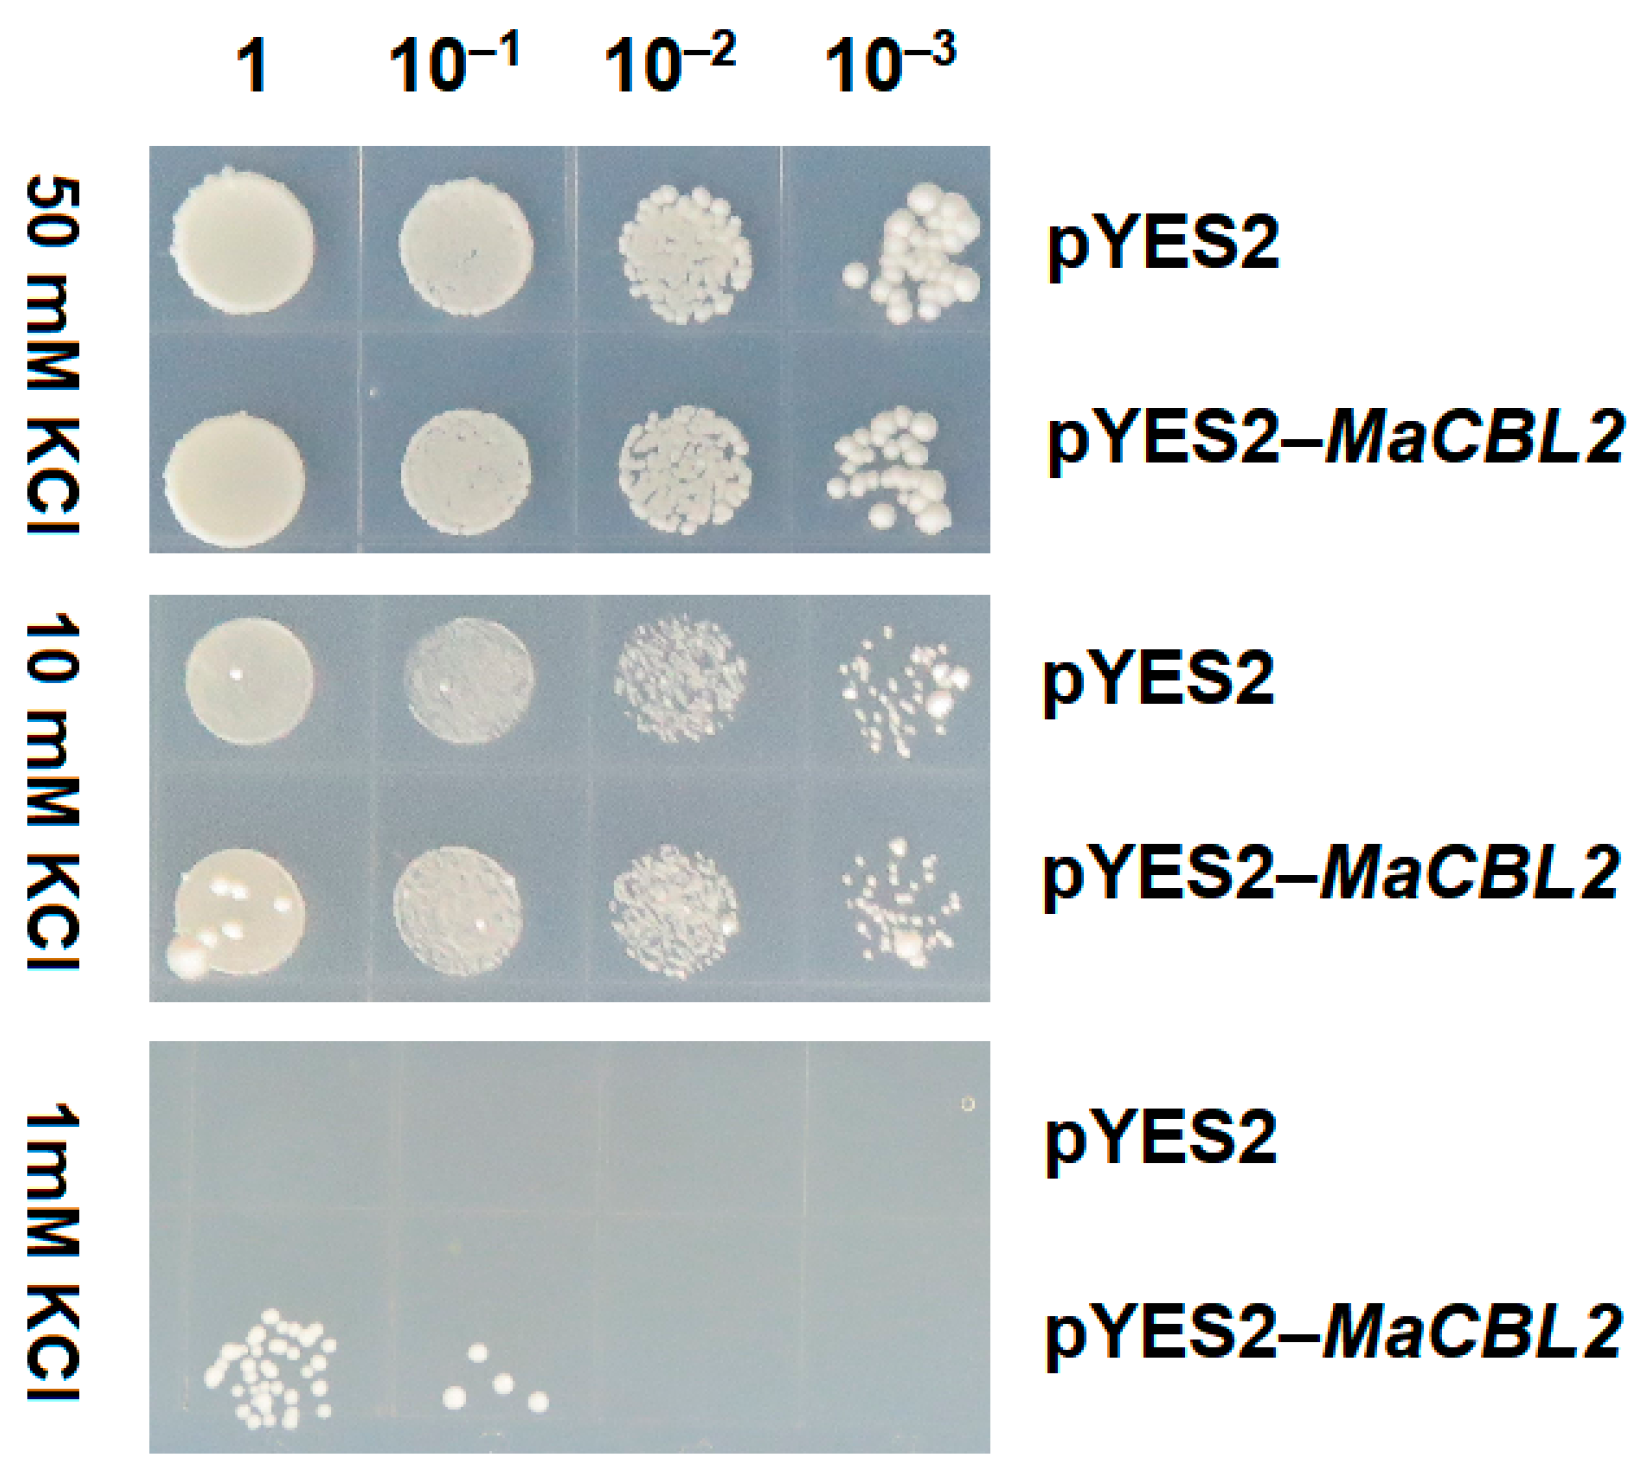
Horticulturae 07 00070 g007 Horticulturae 07 00070 g007

Abstract
Calcineurin B-like (CBL) proteins are reported to play significant roles in plant development and ion-transport regulation. Potassium shortages are a serious problem in banana cultivation. However, to date, the members of the banana CBL gene family, and their function in regulating potassium stress, remain unclear. In this study, 11 CBL genes were identified from the banana genome and grouped into four groups (Group I–IV) based on their phylogenetic relationships. The genomic features of these MaCBL genes were analyzed, focusing on their gene structures, standpat motifs, chromosomal distributions, and evolutionary history. Expression pattern analysis revealed that the MaCBLs were function-specific. Further qRT-PCR analysis indicated that the presence of MaCBL2 was indeed a response to potassium deficiency stress. The MaCBL2 gene was cloned, and sequence alignment indicated that it contained four elongation factor hand (EF-hand) domains, the conserved N-terminal myristoylation domain “MGCXXS/K(T)” and the “FPSF” motif. Subcellular location analysis showed that MaCBL2 was located in the plasma membrane, nucleus and cytoplasm. The overexpression of MaCBL2 could restore the growth of the yeast mutant R5421 on a K+-deficient medium. The overexpression of MaCBL2 could promote the root length of transgenic seedlings on K+-deficient medium. These findings indicate that MaCBL2 was, in our study, the key gene of the CBL family in responding to potassium deficiency in bananas. Our discoveries have established a considerable basis for the further study and application of MaCBL genes.
1. Introduction
Calcineurin B-like (CBL) proteins, a family of Ca2+ transducers, are famous for their interactions with the CBL-interacting protein kinases (CIPK), enacting numerous regulatory roles in plant development and physiological activity according to CBL–CIPK models [1]. CBLs are found in both monocots and dicots, and also belong to a complex, polygenic family. According to published data, the numbers of CBL genes vary between different species. For instance, only 5 CBL members are found in eggplants [2], while there are 8 in pineapples [3], 9 in peppers [4], 10 in both Arabidopsis and rice [5], and 22 in Gossypium hirsutum [6]. Evolutionary analysis has suggested that the number of CBL members in the genome of each species is independent of its genome size [7]. For example, among monocotyledonous plants, the genome size of maize and rice is 2500 and 372 Mbs, respectively, while the number of CBL genes in maize is less than that in rice, which is 9 and 11, respectively [7]. CBLs feature four elongation factor hand (EF-hand) motifs and bear Ca2+-binding sites in their protein sequences [7]. However, the EF-hand structure varies across different CBLs. For example, there is only one unmutated classical EF-hand structure in AtCBL6, -7, -8 and -10, and there two unmutated EF-hand structures in AtCBL1 and AtCBL9, while AtCBL2–5 have no classical EF-hand structure [5]. Although the EF-hand structures of different CBL proteins vary to different degrees, the quantities of EF-hand motifs have remained stable in all the previously studied CBLs [5]. In addition, some CBL proteins contain domains associated with protein interaction and cell anchoring, such as the myristoylation domain [8] and tonoplast-targeting sequences [9].
CBL family genes can be involved in signal transduction either by interacting with CIPKs or in a manner independent of them [10]. The CBL–CIPK model is reported to characterize many forms of abiotic stress response. The CBL4–CIPK24–SOS1 and CBL10–CIPK24–NHX pathways are the two salt-stress signal-transduction pathways in Arabidopsis [11,12], and the CBL1/9–CIPK23–AKT1, CBL3–CIPK9, and CBL4–CIPK6–AKT2 pathways are involved in signal transduction for potassium absorption [13,14,15,16]. Alternatively, CBL1/9–CIPK1 is involved in responding to drought stress, CBL1/9–CIPK26 is involved in the regulation of ROS signals, and CBL2–CIPK7 is involved in the light signaling pathway [17,18,19,20]. Several studies have indicated that some CBL genes can directly activate downstream genes without any association with CIPK genes. For example, AtCBL3 can directly act on its downstream target gene AtMTAN and inhibit its enzymatic activity [21], and AtCBL10 can directly act on AtAKT1 to balance the K+ levels in plant cells [10]. However, previous studies have mainly focused on the model plant Arabidopsis thaliana, and the issue of whether the homologous genes in other plant species have similar functions remains to be investigated.
The banana (Musa acuminata L.) is a traditional fruit tree that grows in tropical or subtropical areas around the world. It typically suffers from potassium shortages during its cultivation. It is well known that potassium availability and supply are vital for the banana and usually the most crucial factors aiding or restricting the physiology and development of the fruit. Decades of research has provided deep insight into the molecular components and mechanisms of potassium-ion absorption, distribution and storage in the plants. Some CBL family members have been reported to control the potassium absorption process [13,14,15,16]; however, whether the CBL family members in bananas have the same function and which one is the key factor remain to be determined. In this study, publicly accessible banana genomic data [22] and our previous transcriptomic data [23] were used to perform genome-wide mining, as well as evolutionary and gene expression analysis, of the CBL family genes. The selected MaCBL2 gene was further cloned from the banana plant and studied for its function in the response to potassium via functional complementarity experiments with yeast mutation and the growth analysis in tobacco transgenic seedlings under potassium shortage treatments. The results provide novel insights into the potassium-deficient stress responses of MaCBL gene members and may be valuable for further understanding the utilization of CBL genes in bananas or other plants.
2. Materials and Methods
2.1. Mining of CBL Genes in Banana Genome
Phytozome13 [24] was employed to search for genes encoding CBL proteins in the banana (Musa acuminata) genome [22]. First, the well-studied CBL protein sequences for Arabidopsis [5] were employed in searching for the homologous proteins in the banana genome through BLASTP. The CBL genes obtained were named MaCBLs and numbered based on their chromosomal locations in ascending order. The gene sequences, annotations and information on chromosome location were obtained from the genomic data. The physicochemical parameters of the MaCBLs were calculated with the ProtParam tool in Expasy (http://web.expasy.org/protparam accessed on 18 January 2021) [25].
2.2. Phylogenetic Analysis and Multiple Sequence Alignment
The sequences of the CBL proteins from banana (Musa acuminata), Arabidopsis thaliana [5], rice (Oryza sativa) [5], pineapple (Ananas comosus) [3], wheat (Triticum aestivum) [26], pepper (Capsicum annuum) [4], cassava (Manihot esculenta) [27], Brassica napus [28], and Populus trichocarpa were collected to perform multiple alignment via ClustalW within the MEGA7 software. The phylogenetic tree was constructed in MEGA7, and the evolutionary history was extrapolated with the neighbor-joining method. Multiple alignment and visualization were performed via the JGI-CIG Jalview procedure in Phytozome [24].
2.3. Gene Structure, Conserved Motif, Chromosome Localization, and Syntenic Relationship Analysis
Conserved motifs in the MaCBL protein sequences were analyzed with the MEME platform (accessed date on 18 January 2021, https://meme-suite.org/meme/tools/meme), and the gene structure map was obtained with TBtools [29]. The combined visualization of the phylogenic tree, the motifs, and the gene structures of the MaCBLs were also achieved with TBtools, as were the visualizations of the chromosome localization and syntenic relationships [29]. The Ka and Ks were calculated with the DnaSP6 software [30].
2.4. Plant Treatments and RNA Extraction
The cultivation and treatment of the banana plants was undertaken in a manner similar to that in our previous report, with some variation [23]. In this study, the banana plants were treated with four potassium concentrations: 0, 0.03, 0.3, and 3 mM K2SO4. After treatment for 30 days, the roots were collected and used for RNA extraction. The RNAprep Pure Plant Kit (TIANGEN BIOTECH (BEIJING) CO. LTD) was used to extract the total RNA. The PrimeScript™ RT reagent Kit with gDNA Eraser (Perfect Real Time) (Takara) was used to reverse transcription of mRNA into cDNA. The obtained cDNA was stored at −20 °C for later use.
2.5. Expression Analysis of MaCBLs
For the integral analysis of the MaCBL genes in terms of their responses to potassium stress, the FPKM (kilobase/million mapped reads) data of the MaCBLs were extracted from our previously derived RNA-seq data (PRJNA589855) [23]. For assessing the expression of the selected MaCBL2 gene in response to potassium-shortage stress, qRT-PCR analysis was performed. The reagents and method were similar to those in a previous report [23]. The MaActin gene was used as the internal reference gene. The specific primer pairs of MaCBL2 and MaActin were QMaCBL2-F: GGCAAACAGGCTACATAGAGCG, QMaCBL2-R: AAGCTCGGAAAGGCCATGCTTA, QMaActin-F: CGAGGCTCAATCAAAGA, QMaActin-R: ACCAGCAAGGTCCAAAC. The Real Time PCR EasyTM-SYBR Green I Kit (FORE GENE) was used to perform the qRT-PCR. The relative gene expression levels were calculated by the 2−∆∆Ct method. In this experiment three biological replicates were performed. Values were presented as mean ± SD. The significance of the data was evaluated using one-way ANOVA (analysis of variance) with Duncan’s multiple range test (DMRT). The significance level was set at p ≤ 0.05 indicated by one asterisk and p ≤ 0.01 indicted by two asterisks.
2.6. Cloning and Function Analysis of MaCBL2
To clone the MaCBL2 gene from banana, the following primer pairs were used for PCR: MaCBL2-F1 (CGGAGACCGTCTTCTCACAG) and MaCBL2-R (ATGCAGTGGTCTGGATTGGA). The Ex Taq (TaKaRa, Dalian, China) was used to perform the RT-PCR reactions. The obtained PCR product was detected by 1% agarose gel electrophoresis and then sequenced by Shenggong company.
For performing the subcellular localization experiment for MaCBL2, the following primer pairs were used to clone the MaCBL2 CDS without the stop codon: MaCBL2-F2 (AGAACACGGGGGACTCTAGAATGGGTTGTGTGTCTTCTAAG) and MaCBL2-R2 (GCCCTTGCTCACCATGGATCCAGTCGTGTCTGGATCATCAC). The obtained sequence was subcloned into the pCambia1300–35S–GFP vector to construct the pCambia1300–35S–MaCBL2–GFP vector, which was subsequently used for the transient transfection of tobacco leaves with Agrobacterium tumefaciens. Green florescence detection was performed with a Laser Scanning Confocal Microscope FV1000 (OLYMPUS) at 488 nm. The pCambia1300-35S-GFP vector was used as the control.
2.7. Functional Complementation of MaCBL2 in Yeast
The following primer pairs were used to clone the MaCBL2 gene for constructing the yeast expression vector: MaCBL2-F3 (CGCGGATCCATGGGTTGTGTGTCTTCTAAGCATG) and MaCBL2-R3 (ATAGTTTAGCGGCCGCCTAAGTCGTGTCTGGATCATC). The obtained PCR product was subcloned into the pYES2 vector to construct the pYES2–MaCBL2 vector. Then, the pYES2–MaCBL2 vector and pYES2 vector (control) were transfected into the yeast mutant strain R5421 (CY162), which is a chemically competent cell line (Shanghai Weidi Biotechnology Co., Ltd.) [31].
To perform the yeast complementation assays, the yeast liquid contained pYES2–MaCBL2, and the pYES2 empty vectors were first cultured in SD-Ura liquid medium at 30 °C to an OD 600 value of about 1.0. The yeasts were collected, washed, and diluted with sterile water by factors of 1, 10−1, 10−2, and 10−3 and then cultured on the AP solid medium with different KCl levels: 50, 10, and 1 mM. Five days later, the growth of the yeast was observed, and photos were taken.
2.8. Functional Identification of MaCBL2 in Tobacco
To further test the function of MaCBL2 in response to potassium deficiency stress, the pCambia1300-35S-MaCBL2-GFP vector was permanently expressed in tobacco. For the tobacco transformation experiment, the agrobacterium contained the vector pCambia1300-35S-MaCBL2-GFP was co-cultivated with the tobacco leaf disks on 1/2 MS medium containing 1 mg/L 6-BA for 3 days, and then transferred to the 1/2 MS medium containing 1 mg/L 6-BA, 50 mg/L hygromycin (hyg), and 500 mg/L carbenicillin (car) for screening for 1 month. After subcultured the callus on the same medium for 1~2 times to get the regeneration plants, the regenerated plants were transferred onto the 1/2 MS medium with 50 mg/L hyg, 500 mg/L car, and 0.1 mg/L NAA for rooting and planting in soil to obtain the T1 seeds. The seeds were grown on the hygromycin containing 1/2 MS medium to screen the homozygous strain.
Wild type and three overexpression MaCBL2 transgenic homozygous lines (OE1~3) were cultured for 5 days and then treated with potassium deficiency stress on 1/2 MS medium without K+ and 1/2 MS medium add 0.05 mM KCl. The seedlings growing on 1/2 MS medium were used as control. The phenotype was observed and photographed after the 15th day of treatment, and the root length was measured. The values were presented as mean ± SD. The significance of the data was evaluated using one-way ANOVA similar to the method in Section 2.5 part.
3. Results
3.1. Identification of MaCBL Gene Members from Banana Genomic Data
In total, 11 CBL-related gene members were initially recognized in the banana genome, all containing the conserved EF-hand motif. Based on their genomic serial numbers, in ascending order, these CBLs were named MaCBL1 to MaCBL11 (Table S1). Their genomic DNA lengths ranged from 1853 bp (MaCBL5) to 10,640 bp (MaCBL11), the coding regions ranged from 588 bp (MaCBL1) to 795 bp (MaCBL4) in length, and the amino acid lengths ranged from 195 aa (MaCBL1) to 264 aa (MaCBL4). Their theoretical molecular weights ranged from 22,475.82 Da (MaCBL1) to 30,476.21 Da (MaCBL4), while their isoelectric points varied from 4.56 (MaCBL3) to 5.19 (MaCBL1)—all below 7, indicating that these banana CBL proteins are rich in strong amino acids. Instability index analysis indicated that three CBLs (MaCBL4, MaCBL5, and MaCBL7) are unstable proteins, as their instability indices were greater than 40, while the others are stable proteins. Hydrophobicity analysis showed that the GRAVY value of MaCBL4 was 0.033, indicating that it is a hydrophobic protein, while the GRAVY values of all the other MaCBLs were negative, indicating they are hydrophilicity (Table S1).
3.2. Phylogeny and Motif Examination of MaCBL Members in Bananas
To assess the evolutionary relationships among the CBLs in banana and other plant species, a phylogenetic tree was constructed (Figure 1). Based on previous studies of CBL proteins in Arabidopsis models, the MaCBL proteins were classified into four groups (Ⅰ–Ⅳ). Four MaCBLs (MaCBL1, 2, 3, and 5) were placed in Group I; MaCBL4 was placed in Group Ⅱ; MaCBL8, 7 and 10 were placed in Group Ⅲ; and MaCBL6, 9 and 11 were placed in Group Ⅳ (Figure 1). From the tree, we can also infer that the MaCBLs in the same group have a close relationship with the CBLs from monocotyledonous species, such as Oryza sativa, Ananas Comosus, and Triticum aestivum, while being slightly further away from the CBLs of dicotyledonous plants, such as Arabidopsis thaliana, Manihot esculenta, Capsicum annuum, Brassica napus, and Populus trichocarpa.
Figure 1.
Phylogenetic tree of banana calcineurin B-like proteins (CBLs), with specific CBLs that characterize different species. Ma, At, Os, Ac, Ta, Ca, Me, Bna, and Pt denote Musa acuminata, Arabidopsis thaliana, Oryza sativa, Ananas comosus, Triticum aestivum, Capsicum annuum, Manihot esculenta, Brassica napus, and Populus trichocarpa, respectively.
To more effectively assess the conservation and diversification of the MaCBLs, 10 putative motifs for each of the MaCBL proteins were predicted. All of the MaCBLs contained motifs 1, 2, and 4, while motifs 3, 5, 6, 7 8, 9, and 10 were present in 10, 9, 7, 2, 6, 2, and 2 MaCBLs, respectively, suggesting that these motifs play specific roles in matching proteins. It was also evident that the motif compositions of MaCBLs in the same group were highly similar (Figure 2A,B).
Figure 2.
Phylogenetic clustering, conserved motifs and exon/intron organization of MaCBL genes. (A) The phylogenetic tree was constructed based on MaCBL proteins. (B) The motifs of each of the MaCBLs, and 10 different motifs, are each denoted by different colored boxes. (C) Exon/intron organization of MaCBLs. Untranslated (UTR) 5′- and 3′-regions are indicated by green boxes, exon regions are indicated by yellow frames, and intron regions are indicated by black lines.
3.3. Exon/Intron Organization within MaCBL Genes
Gene structure is one of the factors that reflects the evolution of a multigene family. Thus, the exon/intron organization of each MaCBL gene was analyzed, revealing that most of the MaCBLs contained eight exons, while MaCBL1 had seven exons, and MaCBL4 contained nine exons (Figure 2C).
3.4. Chromosomal Assignment and Evolutionary Analysis of MaCBL Members
The 11 MaCBL members were disproportionally located across five chromosomes of the banana genome (Figure 3A). Chr1 and chr3 each presented two MaCBLs, chr4 presented four, and chr9 had one, while two MaCBLs were located at unknown chromosomal positions (chrUn). To further investigate the syntenic relationships between the banana CBL genes, a synteny analysis was performed. Two pairs of syntenic genes, MaCBL4–MaCBL6 and MaCBL7–MaCBL8, were found in the banana MaCBLs (Figure 3B). The nonsynonymous (Ka) and synonymous (Ks) substitution rates were calculated to reveal the selective pressure and duplication types of the MaCBL gene pairs. The Ka/Ks ratios of 18 gene pairs were below 1.00, indicating that they exhibited purifying selection, while the Ka/Ks ratios of 25 pairs were greater than 1.00, reflecting that they showed positive selection (Table S2).
Figure 3.
Distribution of CBL genes on chromosomes in bananas (A) and the syntenic relationships (B) of CBL genes.
3.5. Expression Pattern of MaCBLs under Different Potassium Stresses
The RNA-seq data we previously derived were used to reveal the expression patterns of the MaCBLs in bananas after 0, 0.03, 3, and 200 mM K+ stress (Figure 4A). Among the 11 MaCBLs analyzed, the expression of MaCBL5 was very low, or undetectable, after different K+-stress treatments. MaCBL10 showed the highest expression under each treatment; however, there were no significant differences in gene expression among the different treatments. Notably, the expression of MaCBL2 was strongly induced in roots subjected to the 0 and 0.03 mM K+ treatments, with expression levels of 8.23 and 13.20, respectively, while under both the 3 and 200 mM K+ treatments, the expression level was 3.61. The MaCBL2 expression differences between 0 and 3, and between 0.03 and 3 mM K+ were 2.28- and 3.66-fold, respectively. However, the differences in the expression of the other MaCBL genes in the same pairs were no more than twofold.
Figure 4.
Expression tendency analysis of the MaCBL genes in bananas under potassium stress. (A) The expression pattern of MaCBLs in bananas under different potassium-stress levels, based on FPKM data. (B) The relative expression tendency of MaCBL2 as assessed by qRT-PCR. The asterisks indicate statistically significant difference, (*) for p ≤ 0.05, (**) for p ≤ 0.01.
To confirm the responsiveness of MaCBL2 to low-potassium stress, roots cultured in 0, 0.03, 0.3, and 3 mM K+ were collected for qRT-PCR. The results indicated that the MaCBL2 expression levels under the 0, 0.03, and 0.3 mM K+ treatments were all higher than under the 3 mM K+ treatment (Figure 4B). This result was consistent with the rest of the results, and it implies that MaCBL2 may play an important part in the response to low-potassium stress.
3.6. Cloning and Characterization of MaCBL2 Gene
MaCBL2 was cloned for further study because it was induced by low-K+ stress. Its protein was found to contain 216 amino acid residues and have a calculated molecular weight of 24,703.17 Da (Table S1). The protein sequences of MaCBL2 and the CBLs of other species in the same group (Group I), such as AcCBL3 and -4; OsCBL4, -5, -7, and -8; TaCBL4 and -7; and AtCBL4 and -8, were used to perform a multiple alignment analysis. As can be seen from Figure 5, MaCBL2 contained the conserved Ca2+-binding-related EF-hand domains, the N-terminal myristoylation domain “MGCXXS/K(T)”, and the “FPSF” motif, as did most of the homologous proteins in other species.
Figure 5.
Multiple sequence alignment of MaCBL2 and other CBLs from other species. The blue shadow indicates similarity at ≥50%. The black lines indicate the elongation factor hand (EF-hand) domains. The green box indicates the myristoylation site, and the red box indicates the FPSF motif.
3.7. Subcellular Localization Analysis of MaCBL2
To characterize the subcellular positioning of MaCBL2, a pCambia1300–35S–MaCBL2–GFP fusion expression vector was constructed and transferred into tobacco leaf epidermal cells. Confocal fluorescence imaging was used to ascertain the fluorescence. The results indicate that MaCBL2 was located in the plasma membrane, nucleus and cytoplasm, locations similar to those for the GFP control (Figure 6).
Figure 6.
Subcellular localization of MaCBL2 in tobacco leaves. Red arrows and numbers indicate (1) plasma membrane, (2) nucleus, and (3) cytoplasm.
3.8. Functional Complementation Validation of MaCBL2
The potassium-ion-deficient yeast strain R5421 was used to study the function of MaCBL2. The MaCBL2 sequence was subcloned into the pYES2 vector to obtain a pYES2–MaCBL2 vector. The pYES2–MaCBL2 and the pYES2 empty vector (control) were transformed into R5421 for the potassium-stress experiment. The results indicate that there was no visible growth deviation between the control pYES2 yeast and pYES2–MaCBL2 when they were grown on AP medium containing 50 mM K+ (Figure 7). As the K+ concentration was decreased to 10 mM, the MaCBL2-overexpressing yeast grew more successfully than the control yeast. When the K+ concentration was reduced to 1 mM, the control yeast could not grow, while the yeast expressing MaCBL2 could overcome their growth defect under the same conditions (Figure 7). This suggests that MaCBL2 plays a certain role in potassium shortage resistance.
Figure 7.
Growth status of the K+-uptake-defective yeast mutant R5421 expressing pYES2–MaCBL2 and pYES2 (control).
3.9. Functional Identification of MaCBL2 in Tobacco Seedling
To further test the function of MaCBL2 in response to potassium deficiency stress, the pCambia1300–35S–MaCBL2–GFP vector was permanently expressed in tobacco. Three transgenic tobacco lines were used for comparative tests. As can be seen in Figure 8A, the root hairs of transgenic tobacco were more than that of control on 1/2 MS medium, but their root length were similar (Figure 8A,B). When the seedlings were cultivated on potassium shortage 1/2 MS (without K+, or plus 0.05 mM KCl), the root length of the transgenic lines were significantly longer than the wild type tobacco seedlings (Figure 8). These results indicated that overexpression of MaCBL2 gene can improve the root growth of transgenic tobacco under potassium deficiency condition.
Figure 8.
Seedling assay for potassium deficiency. (A): Phenotype differences in the seedling growth after 15 days treatment for potassium deficiency. WT: wild type tobacco; OE1~3: the MaCBL2 overexpressed transgenic tobacco. (B) Differences in root length of potassium deficiency treated tobacco seedlings. The error bar indicates the mean ± SD, (*) indicates the significant difference p ≤ 0.05, (**) indicates the significant difference p ≤ 0.01.
4. Discussion
Studies have suggested that CBL family members play vital roles in regulating signal transduction under abiotic stress, either alone [10,21] or in combination with CIPK [13,14,15,16], in plants. OsCBL4 combined with OsCIPK15 was reported to participate in low-oxygen signaling in rice [32]. BnCBL1 interacted with BnCIPK26 and promoted the high-salinity and low-phosphate resistance of transgenic Arabidopsis [33]. CBL–CIPK complexes have been regarded as the bridge between ROS signaling and Ca2+ signaling in plants, a hypothesis eventually proven by evidence of a CIPK–RBOHF interaction, and the CBL–CIPK26-mediated enhancement of RBOHF produced ROS [19]. The CBL family has, therefore, become a research hotspot in plants.
The CBL family have been systematically studied in several plant species, such as dicotyledonous plants (Arabidopsis thaliana [5], eggplants [2], peppers [4], and cotton [6]) and monocotyledonous plants (rice [5], pineapples [3], and sugarcane [34]). However, none of the studies to date had included a systematic analysis of CBLs in bananas. In this study, 11 CBLs were reported after genome-wide mining for bananas. These were distributed across four main phylogenetic groups (Figure 1), a finding in accord with previous studies on Arabidopsis and rice [5].
As imprints left by evolution, the exon/intron structures in genes are often analyzed in the systematic study of gene families [35,36,37]. In our study, the gene structures of most of the MaCBLs were similar: MaCBL1 only had seven exons, while MaCBL4 contained the maximum, nine (Figure 2). These data suggest that the gene structure of MaCBLs is relatively constant.
Duplication and divergence are the core mechanisms of gene family expansion and evolution [38]. The presence of genes on the same chromosome is referred to as tandem duplication, whereas the location of genes on various chromosomes is referred to as segmental duplication [36]. The Ka/Ks value is one of the measurements for determining the mechanisms of gene duplication evolution, and it has been widely used in recent years [36,39,40]. Our results show that 18 duplication events display a Ka/Ks ratio below 1, while 25 events show a Ka/Ks ratio greater than 1 (Figure 3); these results indicate that these genes went through positive selection [36,39,40].
The CBL family generally contains several functional regions, such as four EF-hand motifs [5], the N-terminal myristoylation domain “MGCXXS/K(T)” [41], and the “FPSF” motif [8,42,43]. In the “FPSP” motif, Ser has been proven to be a necessary CIPK phosphorylation target residue in CBL proteins [42,43]. Here, a AtCBL4 homologous gene MaCBL-2 gene was cloned from banana and the multiple sequence alignment was perform (Figure 5). It was shown that the MaCBL2 protein has four EF-hand domains, which is the same as in most of the CBLs in the same group [44]. MaCBL2 also has the same “FPSP” motif as the proteins in the same group, indicating it can interact with some CIPKs and be phosphorylated. It can also be observed that there is a myristoylation site in MaCBL2; this site has been reported to be important for the CBL’s association with the membrane [41]. Our results also confirmed this sequence analysis via subcellular localization experiments (Figure 6), showing that MaCBL2 can be located on a membrane.
There are numerous reports concerning the key functions of CBLs in regulating the absorption of plant nutrients [45]. The Ca2+-dominated process makes a vital contribution to maintaining the homeostasis of nutrients such as potassium, nitrogen, magnesium, and iron [45,46]. The CBL1/9–CIPK23–AKT1, CBL3–CIPK9, and CBL4–CIPK6–AKT2 pathways have been reported to participate in signal transduction for potassium absorption [13,14,15,16]. There are also some reports on the expression of CBLs in response to low-potassium stress [6,10,47]. In cotton, the expression of GhCBLs was the most affected by low-potassium stress [6]. In Arabidopsis, CBL10 was reduced under low-potassium stress, and it can directly interact with AKT2 to maintain the K+ stability in plant cells [10,47]. In eggplants, low potassium treatment strongly up-regulated the expression level of five SmCBLs. In our study, we found that MaCBL2 was significantly induced by low-potassium stress (Figure 4). Coincidentally, the expression of MaCBL2’s homologues AtCBL4 and TaCBL4 was also involved in the response to low-potassium stress [16,48]. In 2017, two successive and distinct Ca2+ signals were found to be triggered by K+-shortage stress in the roots [49]. One was the transient Ca2+ signature occurred within one minute in the root elongation zone. The second was the sustained Ca2+ signal in the root elongation zone and root hair differentiation zone. The secondary Ca2+ response was involved in plant adaption to potassium shortage conditions [49]. Low potassium stimuli response signals trigger gene transcription and root growth to long-term adaptive response. In Arabidopsis, the AtCBL4 was found to associate with AtCIPK6 to activate the Ca2+ dependent AtAKT2 K+ channel. They found the association between AtCBL4 and AtAKT2 through the growth consistency in the Arabidopsis deficient mutants with the lost AtCBL4 and AtAKT2, respectively. However, the function of CBLs in bananas remains uncertain. In this paper, we proved the function of MaCBL2, a AtCBL4 homologous gene, in response to low-potassium stress in the yeast mutant R5421 and in transgenic tobacco. Overexpression of MaCBL2 enhanced the growth ability of the yeast mutant on potassium deficiency medium (Figure 7). Overexpression of MaCBL2 improved the transgenic tobacco seedling root growth under potassium shortage conditions (Figure 8). Our discoveries indicate that MaCBL2 may play a key role in Ca2+-signal-regulated K+-relevant processes in bananas, and the regulatory mechanisms of this gene require further study.
5. Conclusions
In summary, 11 CBL genes were mined from banana genomic data, and they were phylogenetically clustered into four groups (Groups I–IV). Their genomic features were analyzed, including their gene structures, standpat motifs, chromosomal distributions, and evolutionary history, to identify their genetic attributes. Through gene expression tendency analysis, gene cloning, functional complemental experiments in a potassium-deficient yeast mutant, and overexpression in tobacco, we singled out the gene MaCBL2 and demonstrated that it is associated with the regulation of low-potassium stress.
Supplementary Materials
The following are available online at https://www.mdpi.com/article/10.3390/horticulturae7040070/s1, Table S1: Basic information on the MaCBLs in bananas, Table S2: The Ka and Ks data for the MaCBLs.
Author Contributions
Conceptualization, R.L. and Y.H.; formal analysis, Y.Y., J.L., L.W., X.Y., and Y.L.; investigation, Y.X., R.L., X.L., Y.Z. (Yangjiao Zhou), and F.T.; project administration, Y.H.; supervision, Y.Z. (Yan Zhao) and Y.H.; writing—original draft, Y.X. and R.L.; writing—review & editing, J.G., Y.Z. (Yan Zhao), and Y.H. All authors have read and agreed to the published version of the manuscript.
Funding
This study was funded by the Natural & Scientific Fund of Hainan Province (320MS080), the Central Public-interest Scientific Institution Basal Research Fund for Innovative Research Team Program of CATAS (1630092017002 and 1630092017004), the Earmarked Fund for China Agriculture Research System (CARS-31-19), and the National Key R&D Program of China (2018YFD1000500 and 2019YFD1001105).
Acknowledgments
We thank Guo’s laboratory members, including Yajie Wang, Xiaohua Lu, and Jianyu Zhang for all their assistance with the experiments. We are also grateful for the patience and help of the editors and the reviewers.
Conflicts of Interest
The authors declare no conflict of interest.
References
- Shi, J.; Kim, K.N.; Ritz, O.; Albrecht, V.; Gupta, R.; Harter, K.; Luan, S.; Kudla, J. Novel protein kinases associated with calcineurin B-like calcium sensors in Arabidopsis. Plant Cell 1999, 11, 2393–2405. [Google Scholar]
- Li, J.; Jiang, M.M.; Ren, L.; Liu, Y.; Chen, H.Y. Identification and characterization of CBL and CIPK gene families in eggplant (Solanum melongena L.). Mol. Genet. Genom. 2016, 291, 1769–1781. [Google Scholar] [CrossRef]
- Aslam, M.; Fakher, B.; Jakada, B.H.; Zhao, L.; Cao, S.; Cheng, Y.; Qin, Y. Genome-wide identification and expression profiling of CBL-CIPK gene family in pineapple (Ananas comosus) and the role of AcCBL1 in abiotic and biotic stress response. Biomolecules 2019, 9, 293. [Google Scholar] [CrossRef]
- Ma, X.; Gai, W.X.; Qiao, Y.M.; Ali, M.; Wei, A.M.; Luo, D.X.; Li, Q.H.; Gong, Z.H. Identification of CBL and CIPK gene families and functional characterization of CaCIPK1 under Phytophthora capsici in pepper (Capsicum annuum L.). BMC Genom. 2019, 20, 775. [Google Scholar] [CrossRef] [PubMed]
- Kolukisaoglu, U.; Weinl, S.; Blazevic, D.; Batistic, O.; Kudla, J. Calcium sensors and their interacting protein kinases: Genomics of the Arabidopsis and rice CBL-CIPK signaling networks. Plant Physiol. 2004, 134, 43–58. [Google Scholar] [CrossRef]
- Lu, T.; Zhang, G.; Sun, L.; Wang, J.; Hao, F. Genome-wide identification of CBL family and expression analysis of CBLs in response to potassium deficiency in cotton. PeerJ 2017, 5, e3653. [Google Scholar] [CrossRef]
- Mohanta, T.K.; Mohanta, N.; Mohanta, Y.K.; Parida, P.; Bae, H. Genome-wide identification of Calcineurin B-Like (CBL) gene family of plants reveals novel conserved motifs and evolutionary aspects in calcium signaling events. BMC Plant Biol. 2015, 15, 189. [Google Scholar] [CrossRef] [PubMed]
- Ishitani, M.; Liu, J.; Halfter, U.; Kim, C.S.; Shi, W.; Zhu, J.K. SOS3 function in plant salt tolerance requires N-myristoylation and calcium binding. Plant Cell 2000, 12, 1667–1678. [Google Scholar] [CrossRef] [PubMed]
- Tang, R.J.; Liu, H.; Yang, Y.; Yang, L.; Gao, X.S.; Garcia, V.J.; Luan, S.; Zhang, H.X. Tonoplast calcium sensors CBL2 and CBL3 control plant growth and ion homeostasis through regulating V-ATPase activity in Arabidopsis. Cell Res. 2012, 22, 1650–1665. [Google Scholar] [CrossRef] [PubMed]
- Ren, X.L.; Qi, G.N.; Feng, H.Q.; Zhao, S.; Zhao, S.S.; Wang, Y.; Wu, W.H. Calcineurin B-like protein CBL10 directly interacts with AKT1 and modulates K+ homeostasis in Arabidopsis. Plant J. 2013, 74, 258–266. [Google Scholar] [CrossRef] [PubMed]
- Halfter, U.; Ishitani, M.; Zhu, J.K. The Arabidopsis SOS2 protein kinase physically interacts with and is activated by the calcium-binding protein SOS3. Proc. Natl. Acad. Sci. USA 2000, 97, 3735–3740. [Google Scholar] [CrossRef] [PubMed]
- Kim, B.G.; Waadt, R.; Cheong, Y.H.; Pandey, G.K.; Dominguez-Solis, J.R.; Schultke, S.; Lee, S.C.; Kudla, J.; Luan, S. The calcium sensor CBL10 mediates salt tolerance by regulating ion homeostasis in Arabidopsis. Plant J. 2007, 52, 473–484. [Google Scholar] [CrossRef] [PubMed]
- Wang, Y.; Wu, W.H. Potassium transport and signaling in higher plants. Annu. Rev. Plant Biol. 2013, 64, 451–476. [Google Scholar] [CrossRef]
- Lee, S.C.; Lan, W.Z.; Kim, B.G.; Li, L.; Cheong, Y.H.; Pandey, G.K.; Lu, G.; Buchanan, B.B.; Luan, S. A protein phosphorylation/dephosphorylation network regulates a plant potassium channel. Proc. Natl. Acad. Sci. USA 2007, 104, 15959–15964. [Google Scholar] [CrossRef] [PubMed]
- Liu, L.L.; Ren, H.M.; Chen, L.Q.; Wang, Y.; Wu, W.H. A protein kinase, calcineurin B-like protein-interacting protein Kinase9, interacts with calcium sensor calcineurin B-like Protein3 and regulates potassium homeostasis under low-potassium stress in Arabidopsis. Plant Physiol. 2013, 161, 266–277. [Google Scholar] [CrossRef]
- Held, K.; Pascaud, F.; Eckert, C.; Gajdanowicz, P.; Hashimoto, K.; Corratge-Faillie, C.; Offenborn, J.N.; Lacombe, B.; Dreyer, I.; Thibaud, J.B.; et al. Calcium-dependent modulation and plasma membrane targeting of the AKT2 potassium channel by the CBL4/CIPK6 calcium sensor/protein kinase complex. Cell Res. 2011, 21, 1116–1130. [Google Scholar] [CrossRef]
- D’Angelo, C.; Weinl, S.; Batistic, O.; Pandey, G.K.; Cheong, Y.H.; Schultke, S.; Albrecht, V.; Ehlert, B.; Schulz, B.; Harter, K.; et al. Alternative complex formation of the Ca-regulated protein kinase CIPK1 controls abscisic acid-dependent and independent stress responses in Arabidopsis. Plant J. 2006, 48, 857–872. [Google Scholar] [CrossRef] [PubMed]
- Verslues, P.E.; Batelli, G.; Grillo, S.; Agius, F.; Kim, Y.S.; Zhu, J.; Agarwal, M.; Katiyar-Agarwal, S.; Zhu, J.K. Interaction of SOS2 with nucleoside diphosphate kinase 2 and catalases reveals a point of connection between salt stress and H2O2 signaling in Arabidopsis thaliana. Mol. Cell Biol. 2007, 27, 7771–7780. [Google Scholar] [CrossRef]
- Drerup, M.M.; Schlucking, K.; Hashimoto, K.; Manishankar, P.; Steinhorst, L.; Kuchitsu, K.; Kudla, J. The Calcineurin B-like calcium sensors CBL1 and CBL9 together with their interacting protein kinase CIPK26 regulate the Arabidopsis NADPH oxidase RBOHF. Mol. Plant 2013, 6, 559–569. [Google Scholar] [CrossRef]
- Nozawa, A.; Koizumi, N.; Sano, H. An Arabidopsis SNF1-related protein kinase, AtSR1, interacts with a calcium-binding protein, AtCBL2, of which transcripts respond to light. Plant Cell Physiol. 2001, 42, 976–981. [Google Scholar] [CrossRef] [PubMed][Green Version]
- Oh, S.I.; Park, J.; Yoon, S.; Kim, Y.; Park, S.; Ryu, M.; Nam, M.J.; Ok, S.H.; Kim, J.K.; Shin, J.S.; et al. The Arabidopsis calcium sensor calcineurin B-like 3 inhibits the 5’-methylthioadenosine nucleosidase in a calcium-dependent manner. Plant Physiol. 2008, 148, 1883–1896. [Google Scholar] [CrossRef] [PubMed][Green Version]
- Droc, G.; Lariviere, D.; Guignon, V.; Yahiaoui, N.; This, D.; Garsmeur, O.; Dereeper, A.; Hamelin, C.; Argout, X.; Dufayard, J.F.; et al. The banana genome hub. Database 2013, 2013, bat035. [Google Scholar] [CrossRef]
- He, Y.; Li, R.; Lin, F.; Xiong, Y.; Wang, L.; Wang, B.; Guo, J.; Hu, C. Transcriptome changes induced by different potassium levels in banana roots. Plants 2019, 9, 11. [Google Scholar] [CrossRef] [PubMed]
- Goodstein, D.M.; Shu, S.; Howson, R.; Neupane, R.; Hayes, R.D.; Fazo, J.; Mitros, T.; Dirks, W.; Hellsten, U.; Putnam, N.; et al. Phytozome: A comparative platform for green plant genomics. Nucleic Acids Res. 2012, 40, D1178–D1186. [Google Scholar] [CrossRef] [PubMed]
- Artimo, P.; Jonnalagedda, M.; Arnold, K.; Baratin, D.; Csardi, G.; de Castro, E.; Duvaud, S.; Flegel, V.; Fortier, A.; Gasteiger, E.; et al. ExPASy: SIB bioinformatics resource portal. Nucleic Acids Res. 2012, 40, W597–W603. [Google Scholar] [CrossRef] [PubMed]
- Sun, T.; Wang, Y.; Wang, M.; Li, T.; Zhou, Y.; Wang, X.; Wei, S.; He, G.; Yang, G. Identification and comprehensive analyses of the CBL and CIPK gene families in wheat (Triticum aestivum L.). BMC Plant Biol. 2015, 15, 269. [Google Scholar] [CrossRef]
- Mo, C.; Wan, S.; Xia, Y.; Ren, N.; Zhou, Y.; Jiang, X. Expression patterns and identified protein-protein interactions suggest that cassava CBL-CIPK signal networks function in responses to abiotic stresses. Front. Plant Sci. 2018, 9, 269. [Google Scholar] [CrossRef] [PubMed]
- Yin, X.; Wang, Q.; Chen, Q.; Xiang, N.; Yang, Y.; Yang, Y. Genome-wide identification and functional analysis of the calcineurin b-like protein and calcineurin b-like protein-interacting protein kinase gene families in turnip (Brassica rapa var. rapa). Front. Plant Sci. 2017, 8, 1191. [Google Scholar] [CrossRef] [PubMed]
- Chen, C.; Chen, H.; Zhang, Y.; Thomas, H.R.; Frank, M.H.; He, Y.; Xia, R. TBtools: An integrative toolkit developed for interactive analyses of big biological data. Mol. Plant 2020, 13, 1194–1202. [Google Scholar] [CrossRef]
- Rozas, J.; Ferrer-Mata, A.; Sanchez-DelBarrio, J.C.; Guirao-Rico, S.; Librado, P.; Ramos-Onsins, S.E.; Sanchez-Gracia, A. DnaSP 6: DNA sequence polymorphism analysis of large data sets. Mol. Biol. Evol. 2017, 34, 3299–3302. [Google Scholar] [CrossRef]
- Zhang, H.; Xiao, W.; Yu, W.; Jiang, Y.; Li, R. Halophytic Hordeum brevisubulatum HbHAK1 facilitates potassium retention and contributes to salt tolerance. Int. J. Mol. Sci. 2020, 21, 5292. [Google Scholar] [CrossRef] [PubMed]
- Ho, V.T.; Tran, A.N.; Cardarelli, F.; Perata, P.; Pucciariello, C. A calcineurin B-like protein participates in low oxygen signalling in rice. Funct. Plant Biol. 2017, 44, 917–928. [Google Scholar] [CrossRef] [PubMed]
- Chen, L.; Ren, F.; Zhou, L.; Wang, Q.Q.; Zhong, H.; Li, X.B. The Brassica napus calcineurin B-Like 1/CBL-interacting protein kinase 6 (CBL1/CIPK6) component is involved in the plant response to abiotic stress and ABA signalling. J. Exp. Bot. 2012, 63, 6211–6222. [Google Scholar] [CrossRef] [PubMed]
- Su, W.; Huang, L.; Ling, H.; Mao, H.; Huang, N.; Su, Y.; Ren, Y.; Wang, D.; Xu, L.; Muhammad, K.; et al. Sugarcane calcineurin B-like (CBL) genes play important but versatile roles in regulation of responses to biotic and abiotic stresses. Sci. Rep. 2020, 10, 167. [Google Scholar] [CrossRef] [PubMed]
- Ahmad, M.Z.; Li, P.; She, G.; Xia, E.; Benedito, V.A.; Wan, X.C.; Zhao, J. Genome-wide analysis of serine carboxypeptidase-like acyltransferase gene family for evolution and characterization of enzymes involved in the biosynthesis of galloylated catechins in the tea plant (Camellia sinensis). Front. Plant Sci. 2020, 11, 848. [Google Scholar] [CrossRef]
- Akram, U.; Song, Y.; Liang, C.; Abid, M.A.; Askari, M.; Myat, A.A.; Abbas, M.; Malik, W.; Ali, Z.; Guo, S.; et al. Genome-wide characterization and expression analysis of NHX gene family under salinity stress in Gossypium barbadense and its comparison with Gossypium hirsutum. Genes 2020, 11, 803. [Google Scholar] [CrossRef]
- Feng, X.; Wang, Y.; Zhang, N.; Wu, Z.; Zeng, Q.; Wu, J.; Wu, X.; Wang, L.; Zhang, J.; Qi, Y. Genome-wide systematic characterization of the HAK/KUP/KT gene family and its expression profile during plant growth and in response to low-K(+) stress in Saccharum. BMC Plant Biol. 2020, 20, 20. [Google Scholar] [CrossRef]
- Vision, T.J.; Brown, D.G.; Tanksley, S.D. The origins of genomic duplications in Arabidopsis. Science 2000, 290, 2114–2117. [Google Scholar] [CrossRef]
- Bowers, J.E.; Chapman, B.A.; Rong, J.; Paterson, A.H. Unravelling angiosperm genome evolution by phylogenetic analysis of chromosomal duplication events. Nature 2003, 422, 433–438. [Google Scholar] [CrossRef]
- Fang, X.; An, Y.; Zheng, J.; Shangguan, L.; Wang, L. Genome-wide identification and comparative analysis of GST gene family in apple (Malus domestica) and their expressions under ALA treatment. 3 Biotech 2020, 10, 307. [Google Scholar] [CrossRef]
- Du, W.; Lin, H.; Chen, S.; Wu, Y.; Zhang, J.; Fuglsang, A.T.; Palmgren, M.G.; Wu, W.; Guo, Y. Phosphorylation of SOS3-like calcium-binding proteins by their interacting SOS2-like protein kinases is a common regulatory mechanism in Arabidopsis. Plant Physiol. 2011, 156, 2235–2243. [Google Scholar] [CrossRef]
- Hashimoto, K.; Eckert, C.; Anschutz, U.; Scholz, M.; Held, K.; Waadt, R.; Reyer, A.; Hippler, M.; Becker, D.; Kudla, J. Phosphorylation of calcineurin B-like (CBL) calcium sensor proteins by their CBL-interacting protein kinases (CIPKs) is required for full activity of CBL-CIPK complexes toward their target proteins. J. Biol. Chem. 2012, 287, 7956–7968. [Google Scholar] [CrossRef]
- Kanwar, P.; Sanyal, S.K.; Tokas, I.; Yadav, A.K.; Pandey, A.; Kapoor, S.; Pandey, G.K. Comprehensive structural, interaction and expression analysis of CBL and CIPK complement during abiotic stresses and development in rice. Cell Calcium 2014, 56, 81–95. [Google Scholar] [CrossRef] [PubMed]
- Xi, Y.; Liu, J.; Dong, C.; Cheng, Z.M. The CBL and CIPK gene family in grapevine (Vitis vinifera): Genome-wide analysis and expression profiles in response to various abiotic stresses. Front. Plant Sci. 2017, 8, 978. [Google Scholar] [CrossRef] [PubMed]
- Dong, Q.; Bai, B.; Almutairi, B.O.; Kudla, J. Emerging roles of the CBL-CIPK calcium signaling network as key regulatory hub in plant nutrition. J. Plant Physiol. 2020, 257, 153335. [Google Scholar] [CrossRef] [PubMed]
- Xu, J.; Li, H.D.; Chen, L.Q.; Wang, Y.; Liu, L.L.; He, L.; Wu, W.H. A protein kinase, interacting with two calcineurin B-like proteins, regulates K+ transporter AKT1 in Arabidopsis. Cell 2006, 125, 1347–1360. [Google Scholar] [CrossRef] [PubMed]
- Cheong, Y.H.; Pandey, G.K.; Grant, J.J.; Batistic, O.; Li, L.; Kim, B.G.; Lee, S.C.; Kudla, J.; Luan, S. Two calcineurin B-like calcium sensors, interacting with protein kinase CIPK23, regulate leaf transpiration and root potassium uptake in Arabidopsis. Plant J. 2007, 52, 223–239. [Google Scholar] [CrossRef] [PubMed]
- Lekshmy, S.; Jha, S.K.; Chinnusamy, V.; Sairam, R.K. Cloning and characterization of nutrient deficiency and salinity stress responsive TaCBL4 gene from bread wheat (Triticum aestivum L.). Indian J. Genet. Plant Breed. 2016, 76, 152–158. [Google Scholar] [CrossRef]
- Behera, S.; Long, Y.; Schmitz-Thom, I.; Wang, X.P.; Zhang, C.; Li, H.; Steinhorst, L.; Manishankar, P.; Ren, X.L.; Offenborn, J.N.; et al. Two spatially and temporally distinct Ca2+ signals convey Arabidopsis thaliana responses to K+ deficiency. New Phytol. 2017, 213, 739–750. [Google Scholar] [CrossRef] [PubMed]
Publisher’s Note: MDPI stays neutral with regard to jurisdictional claims in published maps and institutional affiliations. |
© 2021 by the authors. Licensee MDPI, Basel, Switzerland. This article is an open access article distributed under the terms and conditions of the Creative Commons Attribution (CC BY) license (https://creativecommons.org/licenses/by/4.0/).